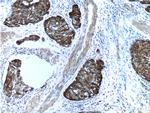
Cytokeratin 14 Antibody in Immunohistochemistry (Paraffin) (IHC (P))
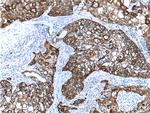
Cytokeratin 14 Antibody in Immunohistochemistry (Paraffin) (IHC (P))

Search
Proteintech
Cytokeratin 14 Polyclonal Antibody
{{$productOrderCtrl.translations['antibody.pdp.commerceCard.promotion.promotions']}}
{{$productOrderCtrl.translations['antibody.pdp.commerceCard.promotion.viewpromo']}}
{{$productOrderCtrl.translations['antibody.pdp.commerceCard.promotion.promocode']}}: {{promo.promoCode}} {{promo.promoTitle}} {{promo.promoDescription}}. {{$productOrderCtrl.translations['antibody.pdp.commerceCard.promotion.learnmore']}}
产品信息
10143-1-AP
种属反应
已发表种属
宿主/亚型
分类
类型
抗原
偶联物
形式
浓度
规格
纯化类型
保存液
内含物
保存条件
运输条件
产品详细信息
Immunogen sequence: GQVGGDVNV EMDAAPGVDL SRILNEMRDQ YEKMAEKNRK DAEEWFFTKT EELNREVATN SELVQSGKSE ISELRRTMQN LEIELQSQLS MKASLENSLE ETKGRYCMQL AQIQEMIGSV EEQLAQLRCE MEQQNQEYKI LLDVKTRLEQ EIATYRRLLE GEDAHLSSSQ FSSGSQSSRD VTSSSRQIRT KVMDVHDGKV VSTHEQVLRT KN (262-472 aa encoded by BC002690)
靶标信息
Cytokeratins (CK) are intermediate filaments of epithelial cells, both in keratinizing tissue (ie. skin) and non-keratinizing cells (ie. mesothelial cells). At least 20 different CKs can be identified. Biochemically, most members of the CK family fall into one of two classes, type I (acidic polypeptides) and type II (basic polypeptides). Belonging to the type I subfamily of low molecular weight keratins and existing in combination with keratin 5, keratin 14 distinguishes stratified epithelial cells from simple epithelial cells and is useful in identification of squamous cell carcinomas. It is considered a prognostic marker in breast carcinomas. At least one member of the acidic family and one member of the basic family is expressed in all epithelial cells.
仅用于科研。不用于诊断过程。未经明确授权不得转售。
生物信息学
蛋白别名: CK-14; cytokeratin 14; Cytokeratin-14; epidermolysis bullosa simplex, Dowling-Meara, Koebner; K14; keratin 14 (epidermolysis bullosa simplex, Dowling-Meara, Koebner); keratin 14, type I; keratin complex 1, acidic, gene 14; Keratin, type I cytoskeletal 14; Keratin-14; Koebner; Type I keratin Ka14
基因别名: AI626930; CK14; EBS1; EBS1A; EBS1B; EBS1C; EBS1D; EBS3; EBS4; K14; Ka14; Krt-1.14; Krt1-14; KRT14; NFJ
UniProt ID: (Human) P02533, (Mouse) Q61781, (Rat) Q6IFV1
Entrez Gene ID: (Human) 3861, (Mouse) 16664, (Rat) 287701